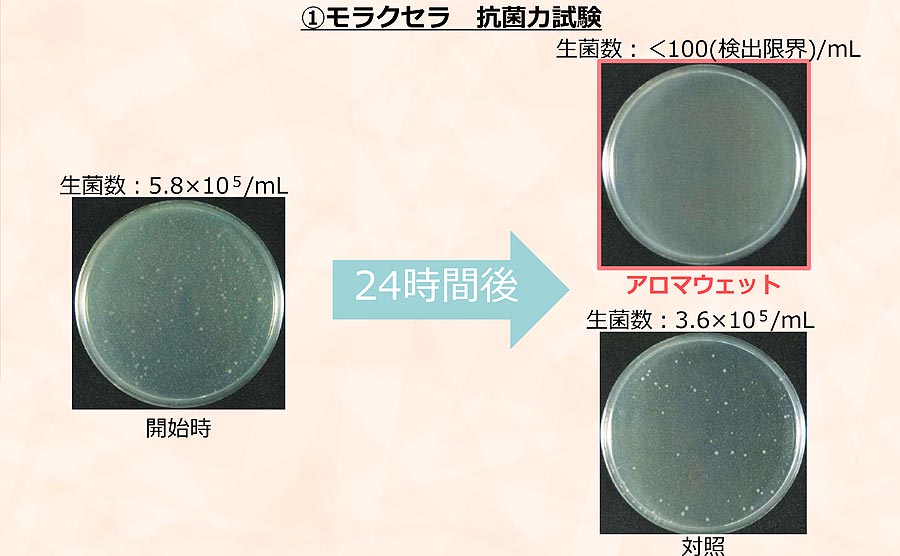
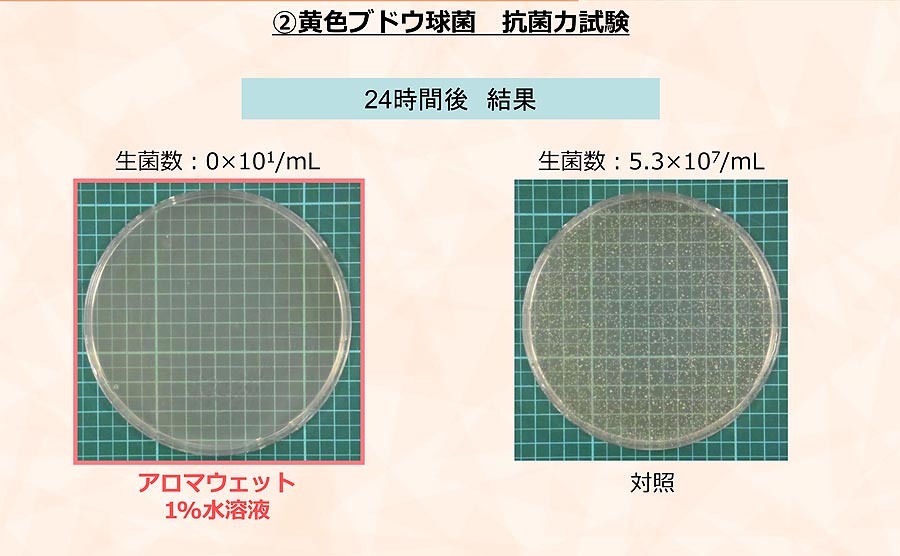
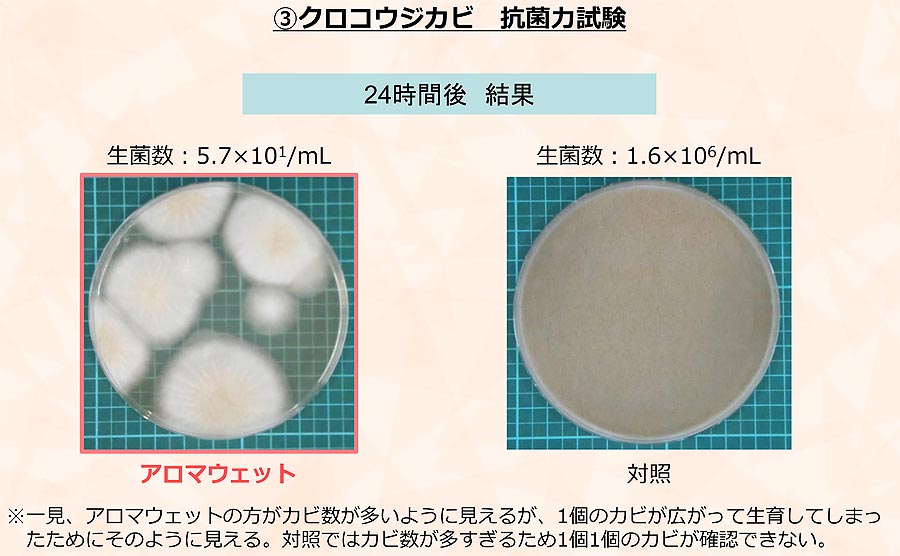

アロマウェット・ボタニカル / オールインワンタイプ
アロマウェット・ボタニカル / オールインワンタイプ
商品の発送・送料について
1.通常商品
10,000円(税別)以上のお買い上げで、送料を無料といたします。
2.サーフボード(沖縄・離島を除く)
| 〜6'9" | 新品 | ¥8,800 |
| USED | ¥9,900 | |
| 6'10"〜 | 新品 | ¥11,000 |
| USED |
※すべて税込
※すべて運送・損害保険付き
※すべて1本あたりの送料
2-1. サーフボード 沖縄・離島
- 着払いで送付します。
- 上記の金額の通りではなく、東京からご自宅までの送料がかかります。
- 別途、梱包料3,300円がかかります。そのため、カートでは配送料として、3,300円と表示されます。
4.配送について
4-1.配送会社
佐川急便で送付いたします。
沖縄、離島および一部地域はヤマト運輸にて送付いたします。
*商品の破損・追跡・不達についての保証ができない為、メール便での発送は承っておりません。ご了承ください。
4-2.配送時間
配送時間は下記よりお選びいただけます。
・午前中
・12時~14時
・14時~16時
・16時~18時
・18時~21時
・19時~21時
4-3.発送時期
サーフボードの発送は、決済確認完了後、通常2営業日以内に発送させていただきます。また、天候や配送時期などの影響や大型荷物配送の都合上、お客様のご指定日は、ご希望通りにお届けできずにご迷惑をおかけする場合もございますので予めご了承頂けるようにお願い致します。
4-4.営業所止め、ご配送先の変更
営業所止めをご希望の方は、ご注文時に備考欄へ記載をお願いいたします。
配送先の変更は発送前であれば、変更が可能です。発送が済んでいる場合は、お客様自身で配送会社への連絡をお願いいたします。
4-5.海外への発送について>
海外への発送はできません。
5.ご不在時の商品保管に関して
商品は、当ショップ出荷後7日間は配送会社にて保管させて頂きます。その間、再配達・電話連絡など配送会社よりご対応致しますが、7日間お客様よりご連絡を頂けない場合は、7日後に当ショップに返送となります。その際には、ご連絡後に再配達の手配を致しますが、当ショップへの返送料と再送料がお客様負担で掛かりますのでご注意下さい。
商品を分割で購入したい
Luvsurfでは、クレジットカードを利用して分割で商品を購入することができます。
ただし、税込1万円以上で、分割払いをご利用いただけます。
また、ボーナス払いには対応しておりません。
1.これまでに、Luvsurfでお買い物をしたことがある方(2025年9月以降)
1. 商品をカートにいれ、「チェックアウト」をクリックしてください

2. メアドの横に表示されています、3点をタップします。
3. 「ゲストとして、チェックアウトします。」を選択します。

4. お支払いのセクションがある、クレジットカード決済(3Dセキュア)-SBPSを選択します。

5.クレジットカード情報を入力し、「支払い回数のメニューから分割払い」を選択します。

6.3Dセキュアの画面に移行しますので、各クレジットカード会社の指示に従って認証を完了させてください。(通常は、メールやSMSで受け取ったコードを入力します。)
2.はじめて、Luvsurfでお買い物をされる方
1.商品をカートにいれ、「チェックアウト」をクリックしてください

2. お支払いのセクションがある、クレジットカード決済(3Dセキュア)-SBPSを選択します。

3.クレジットカード情報を入力し、「支払い回数のメニューから分割払い」を選択します。

4.3Dセキュアの画面に移行しますので、各クレジットカード会社の指示に従って認証を完了させてください。(通常は、メールやSMSで受け取ったコードを入力します。)
ボタニカルシリーズは、従来の洗浄・柔軟効果に加え、ワンランク上の上質な香りが楽しめます。
1回の洗浄でデリケートなウエットスーツを清潔に、しかも柔らかく仕上げる、従来のウエットシャンプーとは一線を画す洗浄剤です。
サーフィン後シャワーを浴びるついでに、AROMAWETでウエットスーツのメンテナンスをしましょう。
大切なウエットスーツを清潔に保ち、長持ちさせる新習慣です。
これ1本でトータルケアOK!
たった20mlで『洗浄』『柔軟』『着香』の3つの効果を実現させるオールインワンタイプのウェットスーツ用リフレッシャーです。
◆洗浄力重視のクリアタイプ(ミステリアスフォレストの香り)
ストロベーリやラズベリーのフルーティーなー香りや
心やすまるほのかに甘いローズの香りが時間とともに
ぬくもりのあるムスクのかおりにかわり ほのかに続きます
◆柔軟重視のミルキータイプ(ラグジュアリーアンバーの香り)
みずみずしく香るレモンやライムの歓喜の香りや
ほんのり甘いピオニーやリリーの香りが時間とともに
暖かみのあるホワイトアンバーの香りに変わり ほのかに続きます
正味量/400ml
◆洗浄+柔軟効果+着香効果。
全く新しいオールイン・ワンタイプのウェットスーツリフレッシャーです。
1回の洗浄でデリケートなウェットスーツを清潔にしかも柔らかく仕上げる従来のウェットシャンプーとは一線を画す洗浄剤です。
サーフィン後、シャワーを浴びるついでに、Aroma Wetでウェットのメンテナンスをしましょう。大切なウェットスーツを清潔に保ち、長持ちさせる新習慣です。
◆ウェットスーツが喜ぶ新習慣!『アロマウェット』がもたらす3つの効果!
<1:ウェットに良い>
水洗いのみだと消臭や除菌効果は期待できず、また生乾きの状態が長く続くとバクテリア、皮脂、たんぱく質が付着したままで異臭の原因になります。『アロマウェット』は洗浄に加えて消臭と除菌、柔軟や着香の効果を発揮。
ふわふわで快適な着用感をキープできるようサポートします。
<2:香りが良い>
大切に扱われてウェットスーツも喜ぶ『アロマウェット』ボタニカルシリーズは洗浄力重視のクリアタイプ(ミステリアスフォレストの香り)と、柔軟重視のミルキータイプ(ラグジュアリーアンバーの香り)の2タイプ。ウェットスーツから漂う心地よいアロマの香りは乾いた後も続くので、自宅の部屋や海へ行く車内で香りを楽しむことができます。
<3:手軽さが良い>
簡単にウェットスーツをリフレッシュできる『アロマウェット』は、自然環境にやさしい成分を使用しているため海上がりの着替え時に洗浄可能。帰宅後のウェットスーツ洗いをカットする手軽さは、すぐにでも疲れたカラダを休ませたいサーファーには嬉しく、今までとは違う新しい習慣をもたらします。
※排水は下水処理できる場所に捨ててください。
◆使い方はこんなに簡単!
必要なものはAroma Wetとポリタンクの20Lの水だけ。
Aroma Wetは1回の押し洗いとたった1回のすすぎだけでOK!
シャワーを浴びた後、ポリタンクに余った水で手軽に質の高いメンテナンスを可能にしました。 


受け取り可能状況を読み込めませんでした
この商品をシェアする
Blog posts
WSLパイプラインPRO「LOSTチームライダー」が大活躍!
WSLパイプラインPRO「LOSTチームライダー」が大活躍! ファイナルヒートは、メンズ4人とウィメンズ4人の合計8人。 8名中、半数の4名がLostサーフボードTEAMライダーでした。 メンズでは、 3位に「グリフィンコラピント」 4位に「イーライ・ハーネマン」 ウィメンズは 優勝が「ガブリエル・ブライアン」 準優勝が「エリン・ブロックス」でした。 世界最強のチーム、彼らは「WHIPLASH」モデルを乗っていたとのことです。
もっと詳しく知る人気企画! ラヴサーフAMライダー『ヒロキ』と、『リイト』のボードレポートが届きましたよ! バリ修行から帰国し、更にレベルアップした『リイト』のライディングをぜひチェックして下さいね!
こんにちは。スタッフのコウヘイです。 定期的にアップしている『ヒロキパパ』と『リイト』のサーフボードレポート。 今回は、1月中旬から1月末までバリ修行に行っていた『リイト』のライディングショットが多数アップされるので ぜひ最後までご覧になって下さいね! こんにちは! 1月中旬から末まで バリ修行に行っていたリイト。 帰国後いきなりフル装備は辛いだろうと思い 千葉南エリアに行って来ました! 波は腰から腹くらいで潮も多く ボヨついた波でした。 久々にリイトの撮影しながらサーフィンを 見学しました! 使用ボードは LOST SURFBOARDS 5'0"『DRIVER 3.0』ROUND TAIL です 2週間ぶりに会ったのですが 少し体格も良くなり、身長が伸びたように 感じました。 バリでは毎日サイズある波で 色々な技の練習が出来たそうです! この日もポケットでのサーフィンを意識しながら ヒットやレイバックなどの練習をしてましたよ! また、カメラマンのTOSHIZOUさんにも撮影していただきました! その後、私も PLACEBO SURFBOARDS 『TABLET THUMB』DURA-FLEX5 5'10" x 20.25" x 2.80" 35.50cl で入水しました ボヨついた波でもテイクオフが速いので楽ちんです! この時期は少しでも波待ちはしたくないので 短時間でたくさん動いてたくさん波に乗れるボード。 サラリーマンの私には本当に最高のボードです! 私はブーツもいらないと感じた千葉南エリア これから寒さも増してきますが 寒さに負けずサーフィンを 楽しんでいきたいと思います! 久しぶりにリイトと夕方の1ラウンド ありがとうございました! 小さい頃から『リイト』のサーフィンを見ているのですが、凄いスピードで上達しています! 『ヒロキ』のDNAを持ち、環境にも恵まれこれからの更なる成長が楽しみですね! 何よりも『リイト』本人のサーフィンへの熱意が感じます。 そして! 流石ラヴサーフAMライダー『ヒロキ』! ポイントノーズなのに爆速の『TABLET-THUMB』を乗りこなし、35.50clらしいパドルとスピード性能を完全にコントロールしてアクションを決めています! やっぱりサーフィンはスピードがとにかく大事ですよね! 次回の『ヒロキパパ』&『リイト』のボードレポートもお楽しみにしていて下さいね!
もっと詳しく知る皆様!ご来店にて沢山の 新品『LOST サーフボード』Made in CALIFORINIA をご購入ありがとうございます!
Aさんは、LOST『SUB DRIVER3.0 』LIGHT SPEED2 とPLACEBO『PARTY PLATTER』DURA-FLEX5 をお選びになりました。いつもパフォーマンスボードをLIGHT SPEEDでカスタムオーダーをしていただいているお客様でSUB DRIVERが新しくなり、気に入っていただいていたLIGHT SPEEDも2に変わったためカスタムオーダーをいただきました。乗った感覚を気に入って複数のボードをLIGHT SPEEDで作っていただいていたため、新しいバージョンのLIGHT SPEED2の感覚がどうなるかを楽しみにされていました。出来上がりのタイミングと同時に小波でも楽しめるボードとしてPlaceboで5'2"PARTY PLATTERをお買い上げいただきました。 Bさんは、LOST『THE RIPPER』POLYESTER MADE IN USAをお選びになりました。現在はLOST『DIABLO X』をご愛用してくださっているのですが、今回はもう少しパフォーマンス性能に優れたサーフボードを探していた所、『THE RIPPER』が気になりラヴサーフにご来店下さいました。サイズ感やUSA製とJAPAN製で迷われましたが、それぞれをご説明させていただき、『DIABLO X』よりも少しリッター値を落としたサイズのMADE IN USAをご購入です。 Cさんは、LOST『3.0STUB DRIVER』POLYESTER MADE IN USA をお選びになりました。毎年自分へのご褒美にカスタムオーダーしてくださるラヴサーフヘビーユーザー様です。ハイパフォーマンスモデルが好みのベテランサーファー様で、今年は『3.0 STUB DRIVER』をカスタムディメンションでオーダーして下さいました。さすが!毎年オーダーくださっているだけあってLOSTを知り尽くしスペシャルなサーフボードが出来上がってきましたね。持った瞬間にビビッときたようで、とても喜んでくださいましたよ! Dさんは、LOST『SUB DRIVER3.0』POLYESTER MADE IN USA と、LOST『SUB DRIVER3.0』BLACK SHEEP BUILT MADE IN USAを、お選びになりました。遠方のお客様ですが、事前にご相談の上、ご来店いただきカスタムオーダーをいただきました。2本は同じ5'10"サイズの「SUB DRIVER3.0」 SWALLOWテールで、よく利用するという静波のサーフスタジアムでの使用を考慮してサイズを選ばれ、性能の異なる2つのテクノロジーをプールでも波のサイズや風の強弱や向きにより選択して乗れるようにするために、2つのテクノロジーPOLYとBLACK SHEEP BUILTでカスタムオーダーをしていただきました。 Eさんは、LOST『SUB DRIVER3.0』LIGHT SPEEDと、LOST『SABO TAJ』POLYESTERを、USAカスタムオーダーで同時に2本オーダーしていただきました。1本はライトスピードテクノロジー1の『SUB DRIVER3.0』スワローテール 。もう1本はポリエスターの『SABO TAJ』モデルです。POLY製のSABO TAJ』は石垣島のビックウェーブ用で6'3"です。写真には写っておりませんが、ボトム側にも同じカーボンストライプを入れて強度を上げてあります。ゴロゴリのリーフブレイク用なので、折れないようにカーボンストラップを両面に追加してあるビックウェーブ仕様です。もう1本のあえてライトスピード1のテクノロジーで制作させてもらったボードは『SUB DRIVER3.0』をダブルウィングスワローテールでカスタムしたボードです。このようにUSAカスタムオーダーであればウィングを追加したりすることもできるので、皆さんぜひご検討下さい。 皆様!ご来店にて沢山の新品『LOST サーフボード』Made in CALIFORINIA をご購入ありがとうございます!
もっと詳しく知る沢山のカスタムオーダーのお問い合わせをいただき誠に有難うございます! その中でもお問い合わせの多い、カスタムオーダー料金の算出方法のご説明です!
こんにちは。スタッフのコウヘイです。 ホームページがリニューアルしてしまったり、1年以上ぶりのカスタムオーダーフェアーという事もあってか、既に多くのカスタムオーダーやお問い合わせをいただいているのですが、その中でも『○モデルをカスタムオーダーするといくらになりますか?』という質問が結構多いので、カスタムオーダー料金の算出方法をご説明させていただきますね! 1、メニューバーをクリック。 2、サーフボードをクリック。 3、LOSTをクリック。 4、ご希望のモデルをクリック。 5、[PRICE]までスクロールする。 MADE IN USAがPOLYESTERベースプライスとなります。 6、[USA カスタムオーダーチャージ INFORMATION]までスクロールする。 DOUBLE DARTやBLACK SHEEP BUILT、LIGHT SPEED2で製作する場合は、 『テクノロジー(素材)』をクリック。 7、レジンカラーやエアブラシカラーは、『USAカスタムオーダーオプション』をクリック。 *カラーやデザインによってプライスは変動します。 カスタムオーダー総額は、 LOST各モデルページのPOLYESTER USAプライスがベースの料金になります。 下記がPOLYESTERのサーフボードをカスタムオーダーした場合です。 『各モデルのPOLYESTER USA プライス+カスタムオーダー料=POLYESTERのカスタムオーダー総額』 *フェアー期間中はカスタムオーダー料¥22,000が無料になります。 *カスタムオーダーは、MADE IN USAのみ可能です。JAPANとVIETNAMはカスタムオーダー出来かねます。 例えば、LOST『BIG RIG DRIVER』POLYESTERをカスタムオーダーする場合 ベースプライス¥180,400(税込)が総額になります。 *カスタムオーダーフェアー中は、カスタムオーダー料¥20,000 ¥22,000(税込)が無料になる為。 例えば、LOST『BIG RIG DRIVER』のBLACK SHEEP BUILTをカスタムオーダーする場合 ベースプライス¥180,400(税込)+BLACK SHEEP BUILT ¥68,000(税込)=¥248,400(税込)が総額になります。 *BLACK SHEEP BUILTの場合は、ボトム面にのみエアブラシカラーを入れることが出来ます。 *カラー数やデザインによって料金は変動致します。 カスタムオーダー料金は、上記の算出方法になります。 各モデルで基本料金が変わりますので、各モデルページを確認して下さいね。 カスタムオーダーボードだけに無料で入れられるラヴーサーフディケールもあるの知っていますか? カスタムオーダーの場合、ストックボードには存在しないオリジナルのサイジングやディケールを採用し、より自分に合ったサイジングやディケールにカスタマイズすることが可能です! ティントやエアブラシを入れなくても、ストックボードでは使われていないディケールのカラーを使い、位置を変えるだけでもオリジナリティーがでるので、周りの友人が同じモデルに乗っていても差別化でき、より愛着が湧くこと間違い無いですよね! カスタムオーダーは常時受け付けておりますので、お気軽にご相談ください。 ラヴサーフは、LOST SurfboardsとPLACEBO Surfboardsの日本総代理店で、『MAYHEM』との28年にわたるリレーションシップにより、日本に入ってくるサーフボードと日本で作られているMade In Japan Qualityの全てを徹底管理しております。 『西井プロ』を筆頭に、日本で一番、LOST Surfboardsに精通したスタッフがあなたのニーズにピッタリハマるマジックボードをカスタムオーダーするお手伝いをさせていただきますので、ラヴサーフ実店舗やお電話、メールなどでご相談下さいね!
もっと詳しく知る